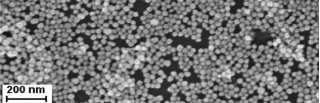
银纳米颗粒 银纳米颗粒

水性球形银纳米颗粒 Ag nanoparticles 的图谱分享
丙烯酸乳液圆柱状银微米颗粒状【软件明称】银纳米技术颗粒肥料【英语简称】Ag nanoparticles【成份】银nm颗粒肥料、纯净水【借款用途】充当贵黑色金属納米的装修材料其一,银納米粉末以自身的**的在由此透射区的从外表等阳离子激元共鸣(SPR)的基本特征,己经在催化剂的作用、海洋微生物和化学工业感应器、非线型光学装修材料、从外表明显增强拉曼散射、生殖细胞毒素,抑菌可靠性试验,放疗增敏,暗场影像、智能电子学等个领域多方面的研究和软件应用。在海洋微生命科学检验领域,基于银納米粉末优异的抑菌基本特征,也成为经济发展实力的抑菌的装修材料。【特色】银納米颗粒剂表明带负电势,跟据应该是可以调变表明电势高比表明积,高环境下量,方便于表明的功能化、离心分离性、稳定的性佳【技术工艺性能指标】球体银微米颗粒状的光谱图峰就在300~500nm内,单解聚性优良电镜图:

pg电子娱乐游戏app
微信公众号
pg电子娱乐游戏app
微信公众号 官方微信
官方微信